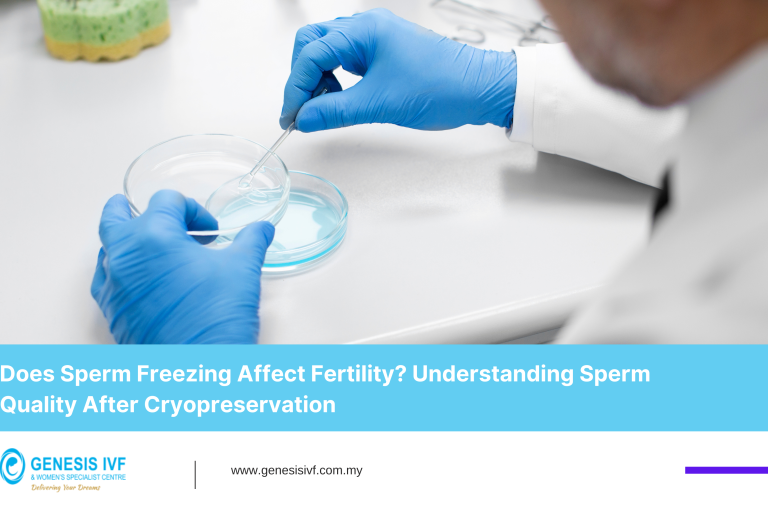
Does Sperm Freezing Affect Fertility Understanding Sperm Quality After Cryopreservation-IVF

Endometriosis and Egg Freezing: Preserving Your Fertility Options Before It’s Too Late
Introduction: A Proactive Choice for Your Future Family If you’ve been diagnosed with endometriosis, you’ve likely heard conflicting advice about your fertility. Some say “try naturally first.” Others warn about declining egg quality. The truth is both simple and urgent: Endometriosis is a progressive condition that can silently damage your ovarian reserve over time. The…